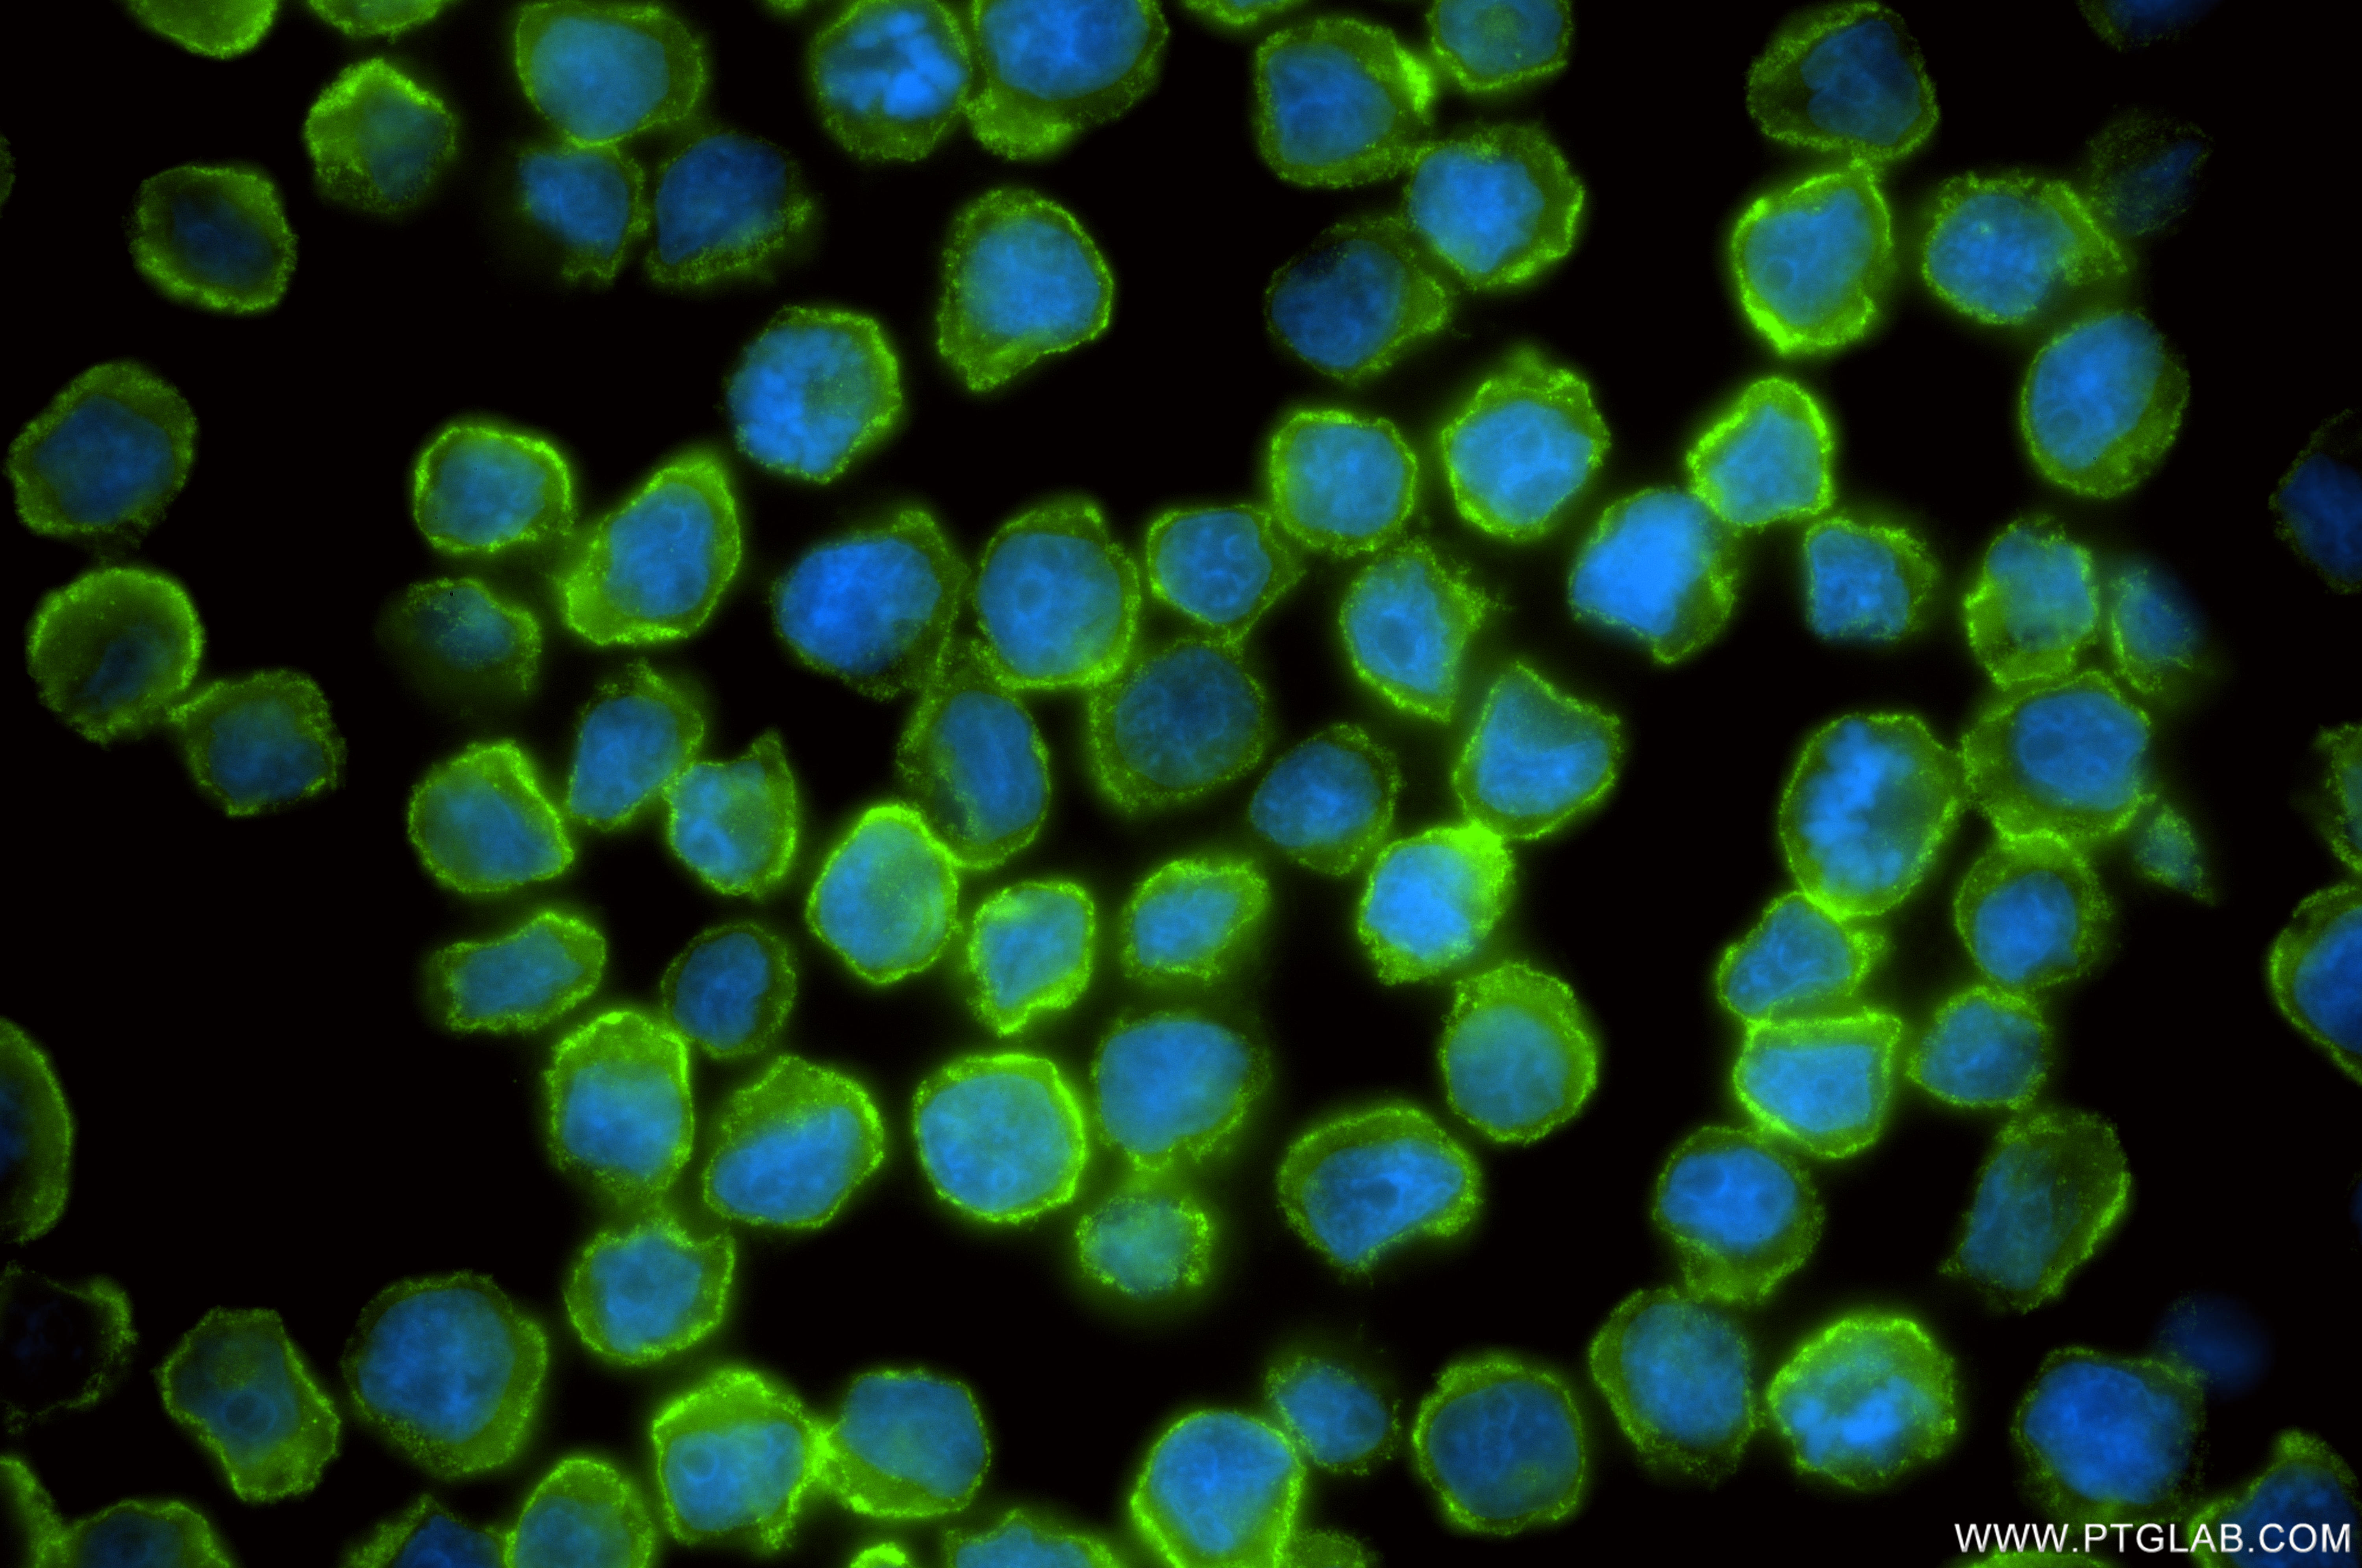
Immunofluorescent analysis of (4% PFA) fixed U-937 cells using CD32 antibody (<a class='green' href='/productredirect?CatalogNo=86588-2-RR' target='_blank'>86588-2-RR</a>, Clone: 251087D9 ) at dilution of 1:200 and CoraLite®488-Conjugated Goat Anti-Rabbit IgG(H+L) (<a class='green' href='/productredirect?CatalogNo=SA00013-2' target='_blank'>SA00013-2</a>). This data was developed using the same antibody clone with 86588-2-PBS in a different storage buffer formulation. IF Staining of U-937 using 86588-2-RR (same clone as 86588-2-PBS)

验证数据展示
产品信息
86588-2-PBS targets CD32 as part of a matched antibody pair:
MP02532-1: 86588-2-PBS capture and 86588-1-PBS detection (validated in Cytometric bead array)
Unconjugated rabbit recombinant monoclonal antibody in PBS only (BSA and azide free) storage buffer at a concentration of 1 mg/mL, ready for conjugation. Created using Proteintech’s proprietary in-house recombinant technology. Recombinant production enables unrivalled batch-to-batch consistency, easy scale-up, and future security of supply.
This conjugation ready format makes antibodies ideal for use in many applications including: ELISAs, multiplex assays requiring matched pairs, mass cytometry, and multiplex imaging applications.Antibody use should be optimized by the end user for each application and assay.
| 经测试应用 | WB, IF/ICC, Cytometric bead array, Indirect ELISA Application Description |
| 经测试反应性 | human |
| 免疫原 |
CatNo: Eg2713 Product name: Recombinant Human FCGR2A/CD32a protein (rFc Tag) Source: mammalian cells-derived, V37 Tag: C-rFc Domain: 34-217 aa of NM_001136219.3 Sequence: QAAAPPKAVLKLEPPWINVLQEDSVTLTCQGARSPESDSIQWFHNGNLIPTHTQPSYRFKANNNDSGEYTCQTGQTSLSDPVHLTVLSEWLVLQTPHLEFQEGETIMLRCHSWKDKPLVKVTFFQNGKSQKFSHLDPTFSIPQANHSHSGDYHCTGNIGYTLFSSKPVTITVQVPSMGSSSPMG 种属同源性预测 |
| 宿主/亚型 | Rabbit / IgG |
| 抗体类别 | Recombinant |
| 产品类型 | Antibody |
| 全称 | Fc fragment of IgG, low affinity IIa, receptor (CD32) |
| 别名 | CD32A, Fc gamma RII a, Fc gamma RIIa, FCG2, Fc-gamma RII-a |
| 计算分子量 | 35 kDa |
| 观测分子量 | 40 kDa |
| GenBank蛋白编号 | NM_001136219.3 |
| 基因名称 | CD32a |
| Gene ID (NCBI) | 2212 |
| 偶联类型 | Unconjugated |
| 形式 | Liquid |
| 纯化方式 | Protein A purification |
| UNIPROT ID | P12318-1 |
| 储存缓冲液 | PBS only, pH 7.3. |
| 储存条件 | Store at -80°C. The product is shipped with ice packs. Upon receipt, store it immediately at -80°C |
背景介绍
CD32 (FcγRII) is a 40 kD transmembrane glycoprotein that binds to the Fc region of IgG with low affinity. CD32 is present on phagocytic cells such as macrophages and neutrophils, and is involved in the process of phagocytosis and clearing of immune complexes.